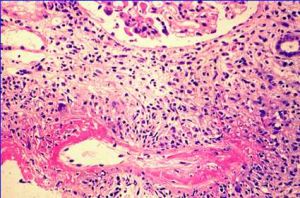
復發性多軟骨炎

流行病學
 復發性多軟骨炎
復發性多軟骨炎病因至今不明可能與外傷、感染、過敏酗酒、服用鹽酸肼屈嗪等有關,也有人認為與中胚層合成障礙或蛋白水解酶異常有關但通過對臨床特點、實驗室檢查和病理的多年研究,越來越多資料提示它是一種免疫介導的疾病,包括體液免疫和細胞免疫。
發病機制
 淋巴細胞
淋巴細胞(1)25%~30%的病例合併有其他自身免疫性疾病,如類風濕關節炎、結節性多動脈炎乾燥綜合徵、系統性紅斑狼瘡貝赫切特病、賴特綜合徵、韋格納肉芽腫、強直性脊柱炎、血管炎等。
(2)病理顯示病變組織有單個核細胞浸潤,特別是CD4+的淋巴細胞和漿細胞。
(3)血清學檢查可發現Ⅱ型膠原的抗體,少數病例還發現Ⅸ和Ⅺ膠原的抗體。部分病例抗核抗體、類風濕因子或循環免疫複合物陽性。
(4)用Ⅱ型膠原免疫嚙齒類動物,可以觀察到耳廓軟骨和多關節軟骨的炎性改變。
 復發性多軟骨炎
復發性多軟骨炎(5)還觀察到患者對軟骨抗原的細胞介導的特異性免疫增強。
(6)通過直接免疫螢光檢查,觀察到在受累的軟骨有免疫球蛋白和補體的沉積。
(7)RP與HLA-DR4相關,與Ⅰ型HLA無關。
(8)Buker等最近報導一種稱為Matrilin-1的抗原可能參與了RP的發病機制,其為一種軟骨基質蛋白,為成人氣管、耳和鼻軟骨所特有。
(9)糖皮質激素或免疫抑制劑治療有效。
綜上所述RP是機體產生了主要針對Ⅱ型膠原的自身免疫反應,造成軟骨破壞此外軟骨糖蛋白、彈性蛋白及其他膠原也可誘發自身免疫反應。軟骨糖蛋白抗原廣泛存在於鞏膜、虹膜睫狀體、氣管、視神經內皮細胞主動脈血管中層結締組織、心臟瓣膜、心肌纖維膜、腎小球基底膜、滑膜等,以證明軟骨糖蛋白抗體可誘發軟骨變性滑膜炎和軟骨膜炎。軟骨糖蛋白還可抑制軟骨細胞糖蛋白的合成,其在RP中的意義還需進一步明確。
2.RP無特異性的病理改變,其病理組織學特點是軟骨溶解伴軟骨膜炎初期軟骨和軟骨膜交界處可見各種急性和慢性炎性細胞浸潤,包括單個核細胞、多核細胞纖維母細胞、血管內皮細胞等隨後軟骨基質內酸性黏多糖減少或消失,軟骨基質變疏鬆,軟骨細胞破壞。疾病進一步發展,軟骨基質壞死、溶解液化,並出現肉芽組織。最後殘餘的軟骨組織消失,肉芽組織纖維化,瘢痕形成收縮,組織塌陷變形。
臨床表現
 表1
表1本病可發生於各個年齡段,而以40~50歲為發病高峰男女均可受累但女性以呼吸道受累較多而較重。復發性多軟骨炎的臨床特徵如(表1)所示。
本病好發於白種人,但世界各地均有本病的報告發病率約為3.5/100萬人。自新生兒至90歲老人任何年齡均可發病,多數發病年齡為40~60歲,無性別及家族性發病的傾向。臨床過程多種多樣多數病例在確診時,已有多系統累及也可突然發作、病情突然加重或呈暴發性發作伴呼吸衰竭。軟骨分布於全身各種組織和器官,通常軟骨炎的表現是多部位的,臨床表現因受累及的部位而各不相同,也因合併的結締組織病或血管炎而不同。主要臨床表現見表2。
1.耳廓軟骨炎:耳廓軟骨炎是最常見的症狀,在39%的病例為首 發症狀以外耳輪突發的疼痛、腫脹發紅髮燙為特徵,炎症可以自行消退或經治療消退。經反覆發作外耳廓變得柔軟而下塌。由於耳前庭結構或內耳動脈血管炎可突發失聽和眩暈。85%病程中受累及起病較突然,常見為對稱性,單側少見急性發作期表現為外耳耳廓紅、腫熱、痛、有紅斑結節。病變可局限,也可瀰漫。病變的嚴重程度不同,持續幾天至幾周然後可自行緩解由於炎症的反覆發作可導致軟骨的破壞、外耳廓鬆弛、塌陷、畸形和局部色素沉著稱為菜花耳。病變局限於軟骨部分而不侵犯耳垂。
2.聽覺及(或)前庭功能受累:病變侵犯外聽道或咽鼓管導致狹窄或閉塞,使聽力受到損害;病變累及中耳和內耳,可表現為聽覺及(或)前庭功能損傷;合併的血管炎累及內聽動脈分支時,也可出現聽覺異常和前庭功能損傷。這些症狀的發生可以是急性或隱匿性的。聽力測驗為35dB神經性或混合性聽力損傷,並常伴有鏇轉性頭暈、共濟失調、噁心及嘔吐。
3.鼻軟骨炎:發生率為63%~82%,常見為突然發病,表現為疼痛和紅腫,數天后緩解如反覆發作可引起鼻軟骨局限性塌陷,形成鞍鼻畸形。甚至有的病人在發病1~2天內鼻樑可 突然下陷病人常伴有鼻塞、鼻分泌物及鼻硬結等。
4.眼炎性病變:發生率達55%。主要表現為眼的附屬檔案炎症,可單側性,也可為對稱性最常見為結膜炎、角膜炎、虹膜睫狀體炎、鞏膜炎和色素膜炎。上述症狀的嚴重程度與其他處炎症常相平行視網膜病變也常有發生如網膜微小動脈瘤、出血和滲出網膜靜脈閉塞、動脈栓塞、視網膜剝離、視神經炎及缺血性視神經炎等。
5.關節病變:多關節炎是本病的第2個常見的初發病症,典型的表現為遊走性、非對稱性、非變形性關節炎,可累及周圍或中軸的大小關節。呼吸道軟骨炎可引致鼻軟骨萎縮塌陷,表現為鞍鼻畸形。喉、氣管及支氣管受累可引致嘶啞、氣梗、甲狀腺軟骨上觸痛咳嗽、喘鳴或喘息。主氣道的萎縮塌陷,常引致呼吸阻塞,並有很高的病死率,需要緊急診斷與處理。嚴重氣道受累的患者,常繼發上下呼吸道感染。發生率70%,可為一過性單發不對稱的大關節病變,也可為持續的多發性對稱性小關節病變。最常累及的關節為掌指關節、近端指間關節和膝關節,其次為踝關節、腕關節、肘關節。也可累及胸骨旁的關節,如肋軟骨、胸骨柄及胸鎖關節等。骶髂關節及恥骨聯合在RP中也可累及關節炎常為突然發作非破壞性及非畸形性,出現局部的疼痛和壓痛,可伴腫脹病變發作數天至數周后自行緩解或抗炎治療後好轉關節的累及與疾病的活動無關。RP病人也可伴有破壞性關節病變疾病,如成人銀屑病關節炎、幼年類風濕關節炎、賴特綜合徵、乾燥綜合徵、強直性脊柱炎等。
6.喉、氣管及支氣管樹軟骨病變:發生率為50%~71%,26%為首發症狀,其中女性多見。而多數患者主訴慢性咳嗽、咯痰繼之氣短,往往被診斷為慢性支氣管炎,歷時6個月至數十年最終出現呼吸困難、反覆呼吸道感染和喘憋有時會出現氣管前和甲狀腺軟骨壓痛、聲嘶啞或失聲症氣道阻塞在早期是炎性水腫;後期出現氣道軟骨環破壞,易於塌陷造成氣道的彈性狹窄;晚期纖維化和疤痕收縮,造成氣道的固定性狹窄;由於氣道纖毛上皮的損傷,對分泌物的清除下降,也可造成阻塞和感染;另外,聲帶麻痹也可造成吸氣性呼吸困難
7.心血管病變:復發性多軟骨炎亦可累及心血管系統,發生率為30%,包括主動脈瘤,主動脈瓣大血管栓塞、小血管或大血管炎症和心臟瓣膜損害,心包炎及心肌缺血等。並可引起死亡。此外,在心血管併發症中還有兩個致命的災禍:一個是由完全性傳導阻滯和急性主動脈瓣閉鎖不全引致的心血管虛脫;另一個是主動脈瓣破裂。大血管受累可引致血管動脈瘤(主動脈、鎖骨下動脈),或由於血管炎或凝血病變而致的血栓形成。小血管受累時則表現為白細胞碎裂性血管炎。一般男性病人主動脈受累常見,表現為主動脈環及降主動脈進行性擴張,有些病例可出現升主動脈瘤胸、腹、主動脈及鎖骨下動脈發生動脈瘤。
8.皮膚:25%~35%累及皮膚,其中10%為首發症狀。復發性多軟骨炎可有多種皮膚黏膜病變,皮損為非特異性的,如結節性紅斑、脂膜炎、網狀青斑、蕁麻疹、皮膚多動脈炎結節及阿夫他潰瘍等。活檢病理常呈白細胞破碎性血管炎皮損的發生率與年齡、性別等無關,合併骨髓異常增生症者皮損發生率為90%。
9.神經系統:第Ⅱ、Ⅲ、ⅣⅥ、Ⅶ及Ⅷ對腦神經的急性或亞急性病變可引致眼肌麻痹視神經炎、面癱、聽覺喪失和眩暈其他神經系統併發症還有偏癱慢性頭疼共濟失調癲癇發作、精神錯亂、痴呆和腦膜腦炎等少數病人有累及,如表現為Ⅱ、Ⅵ、ⅦⅧ腦神經麻痹、小腦性共濟失調、癲癇、器質性腦病和痴呆等,少數報導有顱內動脈瘤形成。
10.腎臟:受累及不多見,約8%,最常見的病理組織類型為輕度系膜增生型和局灶節段瓿月體型腎小球腎炎,其他還有腎小球硬化IgA腎病間質性腎小管腎炎等我院有1例出現間斷性肉眼血尿8個月,並伴有蛋白尿和肌酐清除率下降。多數作者認為有腎臟病變者往往同時合併有其他系統性血管炎疾病。
11.其他:貧血和體重下降是最常見的全身症狀,在急性發作期常伴有發熱。也可出現肌肉疼痛及肝功能損傷等。
併發症:
血管炎是最常見的與RP共存的疾病包括孤立的皮膚白細胞破碎性血管炎和累及多器官的系統性血管炎(表3)。RP
 表3
表3RP與多種形式的結締組織疾病共存,且多數結締組織疾病先於RP發作前的數月至數年,其中最多見為系統性紅斑狼瘡。目前推測RP是結締組織疾病的一部分,在基因學上認為RP是結締組織病的一個分支我院RP病例有合併類風濕關節炎及乾燥綜合徵。
RP與血液系統疾病合併存在主要為骨髓異常增生症,其中多數為男性,半數合併染色體畸形急慢性髓性白血病及再生障礙性貧血均已有報告。有報告個別RP合併有霍奇金病。
RP與甲狀腺疾病的相關性達4%。如合併突眼性甲狀腺腫、非中毒性甲狀腺腫、慢性淋巴細胞性甲狀腺炎(Hashimoto病)、甲狀腺功能低下等。
也有文獻報告RP與潰瘍性結腸炎、原發性膽汁性肝硬化和硬化性膽管炎並存。
診斷
 復發性多軟骨炎
復發性多軟骨炎復發性多軟骨炎的診斷一般是基於臨床特徵,不一定做活組織檢查。McAdam等提出下述診斷標準:對稱性耳軟骨炎,非破壞性、血清陰性多關節炎,鼻軟骨炎,眼炎,呼吸道軟骨炎耳蝸或前庭功能障礙。符合其中至少3項可以成立診斷。如果臨床表現不確定,必須除外其他原因引致的軟骨炎尤須除外感染性疾病。須做活檢和培養或其他必要的試驗以除外梅毒、麻風、真菌或其他細菌感染。
氣管和支氣管的狹窄可用放射成像和CT技術確定。CT掃描是安全快捷、準確的首選的程式。典型的表現,可見到支持性軟骨結構增厚和塌陷而致的呼吸道管腔狹窄影。
其他檢查,如肺功能實驗(尤其是伴有咳嗽和呼吸困難時)、超聲心動圖、心導管、血管造影等在出現心血管症狀和體徵時均應考慮。
1.1975年McAdam關於RP的診斷標準。
符合下述6條的3條或3條以上不須組織學證實,可確診為RP如果臨床上的診斷十分明顯,也可無需軟骨的組織學證實。
(1)雙耳復發性多軟骨炎。
(2)非侵蝕性血清陰性多關節炎。
(3)鼻軟骨炎。
(4)眼炎症、結膜炎、角膜炎、鞏膜炎,外鞏膜炎及葡萄膜炎等。
(5)喉和(或)氣管軟骨炎。
(6)耳蝸和(或)前庭受損。
2.診斷:鑒於本病少見,臨床表現複雜又無特殊的實驗室檢查,因此診斷較困難,通過上述臨床和實驗室資料應考慮到RP的診斷。
Damiani和Levine認為要達到早期診斷,應擴大McAdam的診斷標準,只要有下述中的1條即可診斷:
①滿足3條McAdam征或更多者;
②1條McAdam征加上病理證實,如作耳、鼻呼吸道軟骨活檢;
③病變累及2個或2個以上的解剖部位,對激素或氨苯碸治療有效。
我們認為凡有下列情況之一者應疑有本病:
①一側或兩側外耳軟骨炎,並伴外耳畸形;
②鼻軟骨炎或有原因不明的鞍鼻畸形;
③反覆發作性鞏膜炎;
④不明原因氣管及支氣管廣泛狹窄,軟骨環顯示不清,或有局限性管壁塌陷。再結合實驗室檢查,如尿酸性黏多糖含量增加及抗膠原Ⅱ型抗體存在,將有助於診斷。
鑑別診斷
復發性多軟骨炎
復發性多軟骨炎1.耳廓病變常為RP的首發症狀要與其他孤立的耳廓炎症鑑別,首先包括耳廓的急慢性感染,其次為外傷、凍傷、化學物的刺激昆蟲咬傷、日曬等還應與軟骨皮炎鑑別,該病耳輪周有小結節,病變也累及軟骨的邊緣,其起病是由於血管功能失調所致,病變可反覆發作,與RP極相似。耳廓囊性軟骨化與RP也相似,其在軟骨的中心區有空洞性病損,但臨床上呈無痛性,可伴有腫脹,常發生於耳廓上半部,局部有漿液性滲出。
2.聽力和前庭功能障礙為首發症狀的RP要與腦基底動脈病變和腦卒中鑑別,尤其是突然發作的病例。合併角膜炎時要與Cogan’s綜合徵鑑別,後者多見於年輕人,偶見老人發病常為突然開始於單側或雙側的視物模糊、眼痛流淚、瞼痙攣、耳鳴眩暈、噁心、嘔吐雙側進行性的耳聾、結膜充血及出血、角膜有斑狀顆粒性浸潤等。病變反覆或交替侵犯雙眼但它一般沒有軟骨炎。
3.以鼻軟骨炎為首發症狀的RP需與鼻慢性感染、韋格納肉芽腫、先天性梅毒致死性中線肉芽腫淋巴瘤、結核等引起的肉芽腫鑑別,多次活檢及病原菌的培養可有助鑑別且RP主要為軟骨的炎症,不侵犯軟組織
4.眼炎,因本病眼征表現繁多,應注意病因的鑑別。如壞死性鞏膜炎、角膜炎、關節炎中耳炎伴聽力及前庭功能損害的聯合臨床表現,在韋格納肉芽腫及多動脈炎中也可發生。當RP同時累及眼、關節和心瓣膜心肌時應與類風濕關節炎、貝赫切特病、結節病及血清陰性脊柱關節病鑑別。
5.氣管支氣管瀰漫性狹窄變形應與感染性肉芽腫病、硬結病、氣管的外壓性狹窄、結節病腫瘤、慢性阻塞性肺疾病的劍鞘樣支氣管病、澱粉樣變、先天性氣管和支氣管軟化症等疾病鑑別,一般上述疾病經活組織檢查可明確診斷(圖9,10,11,12)。
6.主動脈炎和主動脈病的病變應與梅毒、馬方綜合徵Ehlers-Danlos綜合徵、動脈粥樣硬化鑑別。
7.肋軟骨炎病變需與良性胸廓綜合徵鑑別,後者如特發性、外傷性肋軟骨炎、Tietze’s綜合徵、肋胸軟骨炎、劍突軟骨綜合徵等上述這些疾病均無系統性臨床表現,以資與RP鑑別。
8.RP關節病變多種多樣,以多個外周小關節受累的要與類風濕關節炎鑑別;以單個大關節受累的要與關節細菌感染、反應性關節炎等鑑別;以一過性遊走性關節疼痛為主要表現的有時會被認為是偽病。RP臨床上可與結締組織病合併存在,使診斷更加複雜。
實驗室檢查
 X線檢查
X線檢查2.血清學檢查,類風濕因子及抗核抗體陽性。梅毒血清學反應假陽性。血循環免疫複合物也常陽性。間接螢光免疫法顯示抗軟骨抗體及抗天然膠原Ⅱ型抗體在活動期一般均陽性,用激素治療後可轉陰性。因此,抗天然膠原Ⅱ型抗體陽性對RP的診斷可能有幫助。尿酸性黏多糖陽性,在疾病發作期可大於正常值4.21倍,其可提示軟骨破壞的程度。
其它輔助檢查:
1.X線檢查:胸片顯示有肺不張及肺炎。氣管支氣管體層攝影可見氣管、支氣管普遍性狹窄,尤其兩臂後伸挺胸側位相可顯示氣管局限塌陷。同時也能顯示主動脈弓進行性擴大,升和降主動脈耳廓、鼻、氣管和喉有鈣化。周圍關節的X線顯示關節旁的骨密度降低,偶有關節腔逐漸狹窄但沒有侵蝕性破壞。脊柱一般正常,少數報告有嚴重的脊柱後凸、關節腔狹窄、腰椎和椎間盤有侵蝕及融合改變。恥骨和骶髂關節有部分閉塞及不規則的侵蝕。
2.CT可發現氣管和支氣管樹的狹窄程度及範圍,可發現氣管和支氣管 壁的增厚鈣化、管腔狹窄變形及腫大的縱隔淋巴結。呼氣末CT掃描可觀察氣道的塌陷程度高分辨CT可顯示亞段支氣管和肺小葉的炎症。氣道的三維重建可提示更多的信息。
心臟超聲檢查可發現升主動脈瘤或降主動脈瘤心包炎、心肌收縮受損、二尖瓣或三尖瓣反流、心房血栓等。心電圖可出現Ⅰ度或完全房室傳導阻滯。
纖維支氣管鏡檢查可直接觀察受累的氣道,可以顯示氣管支氣管樹的炎症、變形、塌陷等進一步明確診斷和觀察疾病的進程。黏 膜可見紅斑、水腫,肉芽腫樣改變或蒼老萎縮。軟骨環破壞者可見呼氣時相應氣道塌陷。可以鏡下取活檢,有助於明確診斷但出血較多,且在評價氣道阻塞程度中的作用不如肺功能,並可能誘發氣道塌陷而窒息死亡。
肺功能通過測定吸氣和呼氣流量曲線顯示呼氣及吸氣均有阻塞分析流速一容積曲線,可得到50%肺活量時的最大呼氣流速和最大吸氣流速這樣可以區別固定性狹窄和可變的狹窄在呼吸困難中所占的比例,及判斷狹窄的位置。
活組織檢查可提供進一步的診斷證據,但如果臨床症狀典型,活組織檢查並不是必須的。活檢的部位可以是鼻軟骨、氣道軟骨、耳廓軟骨等,但活檢後可能激發復發性多軟骨炎的發作,造成新的畸形。故應特別注意,取耳廓軟骨應從耳後入手。
治療
 軟骨炎治療
軟骨炎治療急性氣道梗阻口服糖皮質激素無效者,用甲潑尼龍靜脈衝擊治療已有獲成功的報導。1例腎臟受累的患者,每月行環磷醯胺靜脈衝擊治療,共6個月,腎功得到改善潑尼松加氨苯碸(dapsone)和環磷醯氨聯合治療的反應不一。急性氣道梗阻可能需要氣管切開,必要時須行氣管擴張術嚴重的心瓣膜受累或大血管瘤是外科干預的指征。
RP病人如能早期診斷及時治療,有可能延長病人的存活期,取得較好的療效。治療的選擇主要與症狀的嚴重程度和受累器官的範圍有關,但並無大家統一的治療方案。傳統的治療包括阿司匹林或其他非類固醇抗炎藥、氨苯碸和激素。
1.病情較輕的病人可以選用阿司匹林或其他非類固醇抗炎藥和氨苯碸。Barrancoc首先用氨苯碸治療RP並收到較好的療效。認為氨苯碸在體內可抑制補體的激活和淋巴細胞轉化,也能抑制溶菌酶參與的軟骨退化性變。氨苯碸平均劑量為75mg/d,劑量範圍25~200mg/d,開始從小劑量試用,以後逐漸加量,因有蓄積作用,服藥6天需停藥1天,持續約6個月。氨苯碸主要副作用為嗜睡、溶血性貧血、藥物性肝炎、噁心及白細胞下降等。
2.中重度的患者要選擇糖皮質激素和免疫抑制劑。糖皮質激素不能改變RP的自然疾病過程,但可抑制病變的急性發作,減少復發的頻率及嚴重程度。開始用潑尼松30~60mg/d,在重度急性發作的病例中,如喉、氣管及支氣管、眼、內耳被累及時,潑尼松的劑量可達80~200mg/d。待臨床症狀好轉後,可逐漸減量為5~20mg/d,維持用藥時間3周至6年平均4個月,少數需長期持續用藥。在激素及氨苯碸治療無效時,或病情嚴重的病例,包括鞏膜炎、氣管支氣管軟骨炎、腎小球腎炎或心臟瓣膜受累時,應加用免疫抑制劑,如甲氨蝶呤、環磷醯胺硫唑嘌呤及巰嘌呤等。另有報告對上述治療均失敗的病例經用環孢素A(cyclosporin)可得到緩解
3.其他治療
(1)手術:對具有嚴重的會厭或會厭下梗阻而導致重度呼吸困難的病人,應立即行氣管切開造瘺術,甚至需輔予合適的通氣以取得進一步藥物治療的機會。一般不選用氣管插管,因可引起氣道的突然閉塞死亡如不可避免,要選擇較細的插管。對於軟骨炎所致的局限性氣管狹窄可行外科手術切除但對預後無明顯改善。心瓣膜病變或因瓣膜功能不全引起的難治性心衰時,可選用瓣膜修補術或瓣膜置換術。主動脈瘤也可手術切除。
(2)金屬支架:對多處或較廣泛的氣管或支氣管狹窄,可以在纖支鏡下或X線引導下置入金屬支架,可以顯著地緩解呼吸困難自膨脹式金屬支架有一定的優點,包括容易放置、X線下可見、動態擴張支氣管開口被支架覆蓋也可通氣、在機械通氣時也可放置、支氣管上皮數周后會覆蓋支架而保留黏膜纖毛功能、極少移位、不影響氣管插管等其主要的併發症是咳嗽、咯血、黏液栓氣胸肉芽腫形成、潰瘍等。
(3)其他:對瀰漫性小氣道受累者,有報導經鼻持續氣道內正壓(CPAP)可以緩解症狀要逐步調整呼氣末正壓水平,有報導為10cmH20。對RP合併血管炎、結締組織病、血液病等時,以治療其合併症為主
預後
RP病人如能早期診斷,及時治療,有可能延長病人的存活期復發性多軟骨炎的5年生存率74%,10年生存率55%。常見的死因是感染和心血管病,如系統性血管炎或血管瘤破裂。氣道阻塞伴或不伴感染占死因的10%~28%。僅有48%病例死於復發性多軟骨炎。因惡性腫瘤致死的少見。RP的病人的預後較難判斷。據對112例RP的分析,死亡率為37%,明確診斷後,中位生存期為11年。5、10年存活分別為74%及55%。引起死亡的主要原因是肺部感染、呼吸道梗阻、系統性血管炎和心血管併發症。預後差的指標有:診斷時的病人年齡大、貧血、喉氣管累及、鞍鼻畸形、呼吸道症狀、顯微鏡下血尿等,伴有血管炎和對口服激素反應不好的患者預後更差。
預防
盡一切努力避免挑起機體的免疫反應是預防自身免疫性疾病的關健。
1.消除和減少或避免發病因素,改善生活環境空間,養成良好的生活習慣,防止感染注意飲食衛生,合理膳食調配。
2.堅持鍛鍊身體增加機體抗病能力,不要過度疲勞、過度消耗戒菸戒酒。
3.早發現早診斷早治療樹立戰勝疾病的信心,堅持治療。保持樂觀情緒
4.預防感染,特別要預防鏈球菌感染是自身免疫性風濕病及並發病的重要環節
併發症
眼部表現有視網膜炎、眼外肌麻痹、視盤水腫等。
